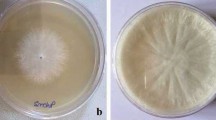

Abstract
Lentil, an important grain legume, is gaining global attention due to its nutritional attributes and minimal water requirement during growth. It is a significant contributor in alleviating micronutrient deficiencies especially in developing nations. The global demand of lentil is increasing, which can be seen as an uptrend in the lentil production during last five decades from 0.85 to 5.73 Mt. Although India is the leading producer and consumer of lentils, the productivity gap is still 30–105% with an average of 42%. Incidence of biotic stresses (especially diseases) is becoming the limiting factor in gaining the optimal productivity and accounts for major yield losses in lentil. Several fungal diseases such as rust, Stemphylium blight, Fusarium wilt, anthracnose, white mold, gray mold, mildews, root rots, etc. are among the major hurdles in obtaining the maximum output from the crop. Management of fungal diseases in crop plants relies on the use of chemical fungicides. However, development of fungicide resistance in many fungi has become an ambush toward sustainable food production. Therefore, exploring the genetic resistance mechanisms along with development of resistant varieties is the best alternative to tackle these problems. Recently, efforts have been made toward disease identification, exploring the genetics and pathway of infection along with the development of disease mitigation strategies in lentil. Wild resistance sources have been identified for several fungal diseases, and a number of varieties have been successfully released which can withstand the impact of the diseases. An understanding of the diseases in lentils, their symptoms, epidemiology, current mitigation practices, and the research progress will help in determining the future research focus which is summarized in this chapter.
Access provided by Autonomous University of Puebla. Download chapter PDF
Similar content being viewed by others
Keywords
11.1 Introduction
Lentil, a diploid (2n = 14) self-pollinating annual crop which is also known as red dahl, masur, massar, etc. is gaining attention due to its nutritive values. The cultivated lentil, Lens culinaris ssp. Culinaris, originated from the wild progenitor Lens culinaris ssp. orientalis (Boiss.) (Ladizinsky 1979). Canada contributes maximum, i.e., four megatons of lentil (25%), to the world lentil pool followed by India, while consumption of lentils is highest in India. Due to the cold tolerance, shorter duration, atmospheric nitrogen fixing (30–40 kg/ha available for next crop) capacity, and increasing demand, lentil became a good substitute for chickpea (Zou et al. 2011). India had a production of 1.51 million tons of lentil from an area of 1.49 million hectares with a productivity of 1008 kg/ha in 2017–2018. Madhya Pradesh is the leading lentil producing state (30.94%) followed by Uttar Pradesh (28.72%), Bihar (15.24%), and West Bengal (5.81%), while Rajasthan has the highest productivity (1408 kg/ha) from the variety CG325 in India (MoA&FW, GOI, 2017–18). Still, 30–105% yield gap has been reported in India with an average of 42% in different production zones (Ali and Gupta 2012)
Lentil is an excellent source of protein having a protein content of 24–26% and is rich in lysine and leucine. Lentil is rich in low fat carbohydrates, oleic, linoleic, palmitic acid, vitamin B, calcium, potassium, etc. and also an outstanding source of macro and micronutrients (Duenas et al. 2006). According to the studies, lentil consumption in regular diet gives immense health benefits and help in protection against the chronic diseases like cardiovascular diseases, coronary heart diseases, cancer, type II diabetes mellitus, and aging (Amarowicz and Pegg 2008).
Stresses can be majorly categorized into two kinds, namely, biotic and abiotic stress. Abiotic stress includes the stresses due to environmental factors such as temperature, water, heavy metals, nutrients, etc., whereas biotic stresses involve the diseases and insect pests and weeds. Crop lentil suffers from major diseases such as rust, anthracnose, gray mold, Fusarium wilt, powdery mildew, root rot, Stemphylium blight, white mold, Ascochyta blight, etc. (Table 11.1) in India, that limit the lentil production; however, it is comparatively free from any kind of serious infestation of insect pests except pod borer (Etiella zinckenella) and aphids (Aphis craccivora). These diseases are discussed with a focus on their causal organism/s, symptoms, epidemiology, and research efforts made toward their mitigation.
11.2 Rust
11.2.1 Introduction
Rust is a foliar disease which is caused by Uromyces viciae-fabae (Erskine et al. 1994). It is a macrocyclic autoecious fungus that exhibits all five spore forms of common rust fungi and is formed on a single host. Rust infection cycle starts in the spring season with diploid teliospores to form four haploid basidiospores of two mating types. Basidiospores after germination produce pycniospores and receptive hyphae. Spermatization and dikaryotization produce aeciospores inside aecia at the abaxial side of the leaf. Germination of aeciospores produces uredia in which urediospores are formed which are brown in color and develop on both sides of the leaflets, pods, and stem (Negussie and Pretorius 2012). Uredia finally differentiate into firm, raised, black-colored telia. Up to 60–69% loss in yield have been reported in India by Singh (1986), while in Ethiopia, a complete crop failure (Beniwal et al. 1993), i.e., up to 100% yield loss, has been reported (Negussie et al. 2005).
11.2.2 Disease Symptoms
The disease initiates with the development of yellow to white pycnidia and aecia (cup like structure) below the leaflet and pod surfaces, independently or in little groups in a circular pattern as described by Agarwal et al. (1993). Afterward, brown uredo pustules show up on both the surfaces of pods, stem, and leaflets. Pustules are round to oval with about 1mm diameter. They can unite into bigger pustules (Fig. 11.1). Late in the season, dark brown- to black-colored teliospores are formed which are elongated and generally present on the stem (Bayaa et al. 1997). The plant has a dim earthy colored to blackish appearance, obvious in influenced regions field or throughout the field if completely tainted (Beniwal et al. 1993). Under extreme contamination conditions, leaves are shed off and wrinkle, or no seed is found in the pods (Dikshit et al. 2016).
11.2.3 Epidemiology
The infection as a rule begins with low patches in the meadow and emanates to outskirts (Bayaa et al. 1997). For recurrence, lentil seed might be debased with rust-contaminated leaf, stem, and pericarps, which in many years can fill in as the essential inoculum for disease (Agarwal et al. 1993; Khare 1981). In weedy hosts, rust can likewise be proceeded from which it can contaminate the field lentil crop with the help of teliospores in the breeze. The disease is favored by high RH, shady, or rainy climate with a temperature range of 20–22 °C (Bashi and Rotem 1975). During the early blooming time frame/podding, the disease peaks up. Aeciospores sprout at 17–22 °C and taint different plants that help in formation of secondary aeciospores at 17–22 °C or urediospores at 25 °C. The uredosori grow later in the season and are immediately trailed by teliospores (Beniwal et al. 1993). The aecia and uredia present in the lentil litter bite the dust after harvesting; however, the teliospores endure high temperatures and permit the survival of disease inoculum throughout the year. Uredospores can be significant means for survival at low-temperature conditions (Bayaa et al. 1997). The uredo mycelium is profoundly impervious to warmth and daylight and is probably going to be significant for the fungus to survive in hot and dry conditions. The teliospores sprout without a break at 17–22 °C and cause new flare-ups of the infection every season. Altogether, 70 enrolled hosts of U. viciae-fabae are found to affect legumes including lentils. Chickpeas, Lathyrus spp., and Vicia spp. are among them.
11.2.4 Mitigation Strategies
As of now, suggested cultural control strategies for controlling U. viciae-fabae include summer volunteer plants control; distancing old host stubble from seasonal crops; and annihilation of old stubble (Prasada and Verma 1948). Previously, Agrosan (phenylmercury acetate)-treated seeds found to be used to control the lentil rust in India (Prasada and Verma 1948). Vigil (diclobutrazol) forestalled the presence of U. viciae fabae as long as 70 days after inoculation and applied as a fungicide for seed treatment (Singh 1985). Analyses exploring the utilization of foliar fungicides to control rust by Agarwal et al. (1977) identified that Hexaferb (ferric dimethyldithiocarbamate) and Dithane M-45 both give the best mitigation over U. viciae-fabae as tested in the test plots in Jabalpur, India. Likewise, Dithane M-45 additionally expanded bundle yield by 82% and grain weight by 24% contrasted with untreated control because of extreme disease when left untreated. The use of resistant varieties is one of the best methods for controlling rust (Bayaa et al. 1997).
Singh et al. (1995) have shown the variability in the pathogen and its pathogenicity. Effective rust-resistant donors such as ILL6002, ILL4605, ILL5604, ILL358, and ILL6209 have been identified in the hotspots, i.e., India, Pakistan, and Ethiopia (Bejiga et al. 1995; Singh and Sandhu 1988). The most commonly used donor for rust resistance in South Asia was Precoz. As described by Sinha and Yadav (1988), the resistance to rust in lentils is controlled by a single dominant gene. Studies reported that F, S, K, Zn, Cu, and Fe predominantly present on the leaf surfaces with excess N, Mn, amino acids, and sugars in the resistant cultivars than the susceptible ones; no difference has been reported on structural basis between resistant and susceptible cultivars (Reddy and Khare 1984). Chahota et al. (2002) studied the inheritance of rust resistance in two crosses of lentil and concluded that two duplicate dominant genes control the resistance. Various markers and genes were identified by the scientists which are linked with rust resistance such as SRAP marker F7XEM4a (Saha et al. 2010a, b), SSR marker Gllc 527 at 5.9 cM distance (Dikshit et al. 2016), genes urf1, urf2, urf3 (Kumar et al. 2001), etc. Gupta et al. (2012) constructed a linkage map for two parents of the lentil population for the rust resistance trait using 199 markers (SSR, ISSR, and RAPD). Among the rust-resistant varieties developed around the world, Barimasur 4 in Bangladesh (Sarker et al. 1999a, b), Pant lentil 4 in NE India (Singh et al. 1994), Assano and Teshale in Ethiopia (Fikre et al. 2007), NIAB masor 2006 in Pakistan (Sadiq et al. 2008), and Calpun-INIA in Chile (Peñaloza et al. 2007) are important ones. Asghar et al. (2018) selected 466 lentil genotypes for resistance to potential fungal diseases and identified LPP 11002 as highly resistant to rust. Kumar et al. (2015) developed seven lines of elite lentils (LL1217, LL1218, LL1219, LL1239, LL1240, LL1241, and LL1243) that were highly resistant to rust.
11.3 Stemphylium Blight
11.3.1 Introduction
Stemphylium botryosum is the causal organism of Stemphylium blight of lentil. It is among the major diseases of lentil which has been reported in Northeast India (Sinha and Singh 1991) and caused about 42% loss in the yield in Bangladesh (Bakr 1991). According to Sinha and Singh (1993), about 83% disease intensity and more than 90% yield loss have been reported in Bihar, India. Recently, the disease has also been reported in Canada and Nepal. The conidia of Stemphylium botryosum has 1–3 transverse and 1–3 longitudinal septa with occasional constrictions at the septation point and are ovoid to subdoliiform with pale brown to brown in color. Asci contains about eight ascospores and are cylindrical to club shaped. Ascospores are seven septate and ellipsoid to club-shaped and yellowish brown in color (Booth and Pirozynski 1967).
11.3.2 Disease Symptoms
The disease symptom begins with light brown to tan-colored spots on the leaflets with pin heads. The small spots then merge and cover the entire leaflet in 2–3 days under the favorable conditions. Lighter and darker angular areas are spread over the entire leaflet which appears light cream color in the infected tissue (Fig. 11.1) (Morrall 2003). Leaving the terminal leaflets, all leaflets shed off rapidly, and the plant turns dull yellow gradually with the spread of disease (Bakr 1991). The stem then dries, slowly turns ashy white, and bends down leaving the green pods on the plant with occasional white mycelium visible on the stem.
11.3.3 Epidemiology
Resting mycelia or the air-borne ascospores serve as the primary inoculum which comes from the infected plant debris or the seed or the weedy host. Although the seed-borne inoculum and its significance are not clearly understood (Mwakutuya 2006), according to Nasir and Bretag (1997), the pathogen has been often isolated from the lentil seeds in Australia. The inoculum is also supposed to be spread through the sea (Booth and Pirozynski 1967) from its weedy hosts such as alfalfa (Gilchrist 1990). A temperature range of 8–22 °C with canopy RH of 94% is favorable for the spread of infection (Bakr 1991), while according to Sinha and Singh (1993), relative humidity of 85–90% and about 18 °C average temperature in the morning are ideal for disease development. According to Mwakutuya (2006), temperature above 25 °C coupled with 48 h of leaf wetness optimizes the symptom development of S. botryosum. The large host range of the pathogen includes lentil (Bakr 1991), alfalfa, clover (Smith 1940), and tomato (Bashi and Rotem 1975). The disease has also been reported in lupin (Tate 1970), spinach (Koike et al. 2001), apple, gladiolus, and onion (Booth and Pirozynski 1967).
11.3.4 Mitigation Strategies
The major inoculum source of this disease is the infected debris and the stubble. Hence, destruction of crop residues and crop rotation are the major cultural methods to control the disease and to decrease the inoculum load. Delayed sowing although reduces the overall yield, but it was found to control the infection of Stemphylium botryosum positively in Bangladesh; but again, it invites the heavy infection of rust (Bakr 1991). Foliar fungicides such as Royal 50 WP were found to be very effective in controlling the damage due to this disease when applied thrice in weekly interval starting from the incidence of disease (Bakr 1991). L. ervoides, L. tomentosus, L. nigricans, L. odemensis, L. lamottei, and L. culinaris ssp. orientalis were found to be the resistance sources of Stemphylium blight (Podder et al. 2013). The resistance is also found to be associated with the morphological traits such as thicker cuticle, epidermal cells, and cortical cells with increase in epidermal hair density (Chowdhury et al. 1997). Barimasur 3 and Barimasur 4 were released in Bangladesh as resistant varieties to this disease (Sarker et al. 1999a, b).
Saha et al. (2010a, b) have done wonderful work for identifying the markers related to disease resistance and constructed a linkage map using 139 markers (RAPDs, SSRs, and SRAPs). He detected a QTL (QLG480–81) and reported a tightly linked SRAP marker (ME4XR16c) that is associated with resistance to S. botryosum. In 2017, Bhadauria et al. (2017) used 2180 high-quality SNPs to construct a linkage map and identified three QTLs (qSB-2.1, qSB-2.2, and qSB-3) for resistance to Stemphylium blight. “Barimasur-3” was released as resistant variety for both rust and Stemphylium blight diseases (Sarker et al. 1999a, b). Barimasur 4 and Binamasur 7 were released in Bangladesh as resistant varieties to this disease (Roy et al. 2018). A complex (Mihov and Stoyanova 1998) and quantitative control of resistance to this disease and its inheritance were studied by Kumar (2007) using a RIL population derived from cross between Barimasur 4 and CDC Milestone.
11.4 Fusarium Wilt
11.4.1 Introduction
Except Australia, Fusarium wilt is present and causes losses to lentil almost in every country and continent especially in rainfed areas (Beniwal et al. 1993). According to Chaudhary and Kaur (2002), this disease can cause severe loss, i.e., up to complete crop failure in certain areas under the favorable conditions. Due to difficulty in identification of species in Fusarium, many causal organisms were reported for this disease and which describe many wilting and dying symptoms (Khare 1981). As far as the vascular wilt of lentil is concerned, the causal organism is Fusarium oxysporum f.sp. lentis. In in vitro culture conditions, the mycelia of pathogen are branched, septate and hyaline. The pathogen produces microconidia, macroconidia, and chlamydospores (Khare 1980). Losses due to this disease vary depending upon the crop stage and its extent. Generally 5–12% loss and 72% loss in Syria (Bayaa et al. 1986) have been reported, while a complete crop failure has been reported in India at seedling stage (Khare 1981). 50–78% loss in India has been reported at pod filling stage (Agarwal et al. 1993), while 8.8% loss for 10% wilted plants has been reported in Syria (Erskine and Bayaa 1996).
11.4.2 Disease Symptoms
Disease symptoms for vascular wilt include stunting of the plants along with curling and shrinking of leaves at the lower parts of infected plant. Leaves at top also show symptoms like water deficiency. In progression, the symptoms come to the stem, and it becomes yellow and the plant dies (Fig. 11.1). Brown-colored discoloration and reduced growth are symptomatic to the root. Tap root tips are injured, and above it, the secondary roots start to flourish. In the lower stem, vascular streak is not always evident. Although the disease has been reported to cause damage at reproductive or pod filling stage, in India, this disease has also been reported in the seedling stage. At seedling stage, the symptoms mostly resemble to that of root rot and damping off which also includes sudden drooping of the plant and sometimes seed rot. External fungal growth near the root zone indicates the presence of other saprophytic fungus such as fungus of collar rot (Khare 1980).
11.4.3 Epidemiology
F. oxysporum f.sp. lentis is a soil-borne pathogen (Chaudhary and Kaur 2002) with a limited host range which is only lentil (Khare 1980). The disease proliferates and spreads at average temperature of 22–25 °C with a warm and dry condition (Erskine and Bayaa 1996). Chlamydospore is the resting structure of the pathogen, and it can survive in the soil for several years without a suitable host. De et al. (2001) found a synergistic collaboration between F. oxysporum f.sp. lentis and Meloidogyne javanica in both susceptible and the resistant cultivars which results in reduction in nodulation, root, and shoot length. Also the presence of the nematode Meloidogyne increases the wilt incidence (De et al. 2001).
11.4.4 Mitigation Strategies
Crop rotation and destruction of infected plants are the important cultural control methods. The released lentil cultivars, OPL 58, DPL 61, and DPL62 which are resistant or moderately resistant to the wilt, should be used (Chaudhary and Kaur 2002). Early maturing varieties or early sowing help in escaping the wilt by escaping the favorable conditions to some extent. Seed treatment also helps in mitigating the disease. According to the study by El-Hassan and Gowen (2006), talc and glucose formulation of biocontrol agent Bacillus subtilis is very effective in controlling the disease there by increasing the root length.
Kumar et al. (2010) identified 325 resistant accessions of lentil out of 20000 lines which were screened in a wilt sick plot. High level of resistance was also observed in wild species, Lens culinaris ssp. orientalis (ILWL 113) and L. culinaris ssp. ervoides (ILWL 138) (Table 11.2). According to Bayaa et al. (1995), utilization of resistance sources such as ILL5883, ILL5588, ILL4400, and ILL590 has been used widely in various countries as a resistance source to Fusarium wilt to develop a number of improved varieties. Lack of stable resistance, effective screening techniques, and appearance of other diseases such as collar rot, dry root rot, etc. are the main hurdle in the progress of development of an effective resistance source against the Fusarium wilt. Some prominent wilt resistant varieties are such Talya 2, Hala, and Rachayya in Lebanon; Idleb 2, 3, 4, and Ebla 1 in Syria; IPA 98 in Iraq; Pant L406, Pant L4, Priya, Seri, JL3, Noori, and VL507 in India; Assano, Alemtina, and Teshale in Ethiopia; and Firat 87 and Syran 96 in Turkey.
Chaudhary (2008) identified 43 cultural and morphological groups by studying on 333 isolates from various states of India. On the basis of disease reaction against 7 different lentil differentials, these 43 isolates were clustered in 3 clusters. Similar study by Datta et al. (2009) identified two subpopulations on molecular analysis of 24 isolates from NE-Indo-Gangetic plains with the help of 12 SSR marker pairs and 40 RAPD markers. Kamboj et al. (1990) reported five genes to confer resistance against Fusarium wilt which are independent of each other. Two duplicate genes in PL 234 and two complementary genes in PL 286 and JL 446 and a single dominant gene have been reported by ICARDA scientists to control wilt resistance (Abbas 1995).
Monogenic inheritance pattern of wilt resistance gene Fw has been recorded by Eujayl et al. (1998) in the variety ILL 5588. He also identified a RAPD marker OPK-15900 (10.8 cM) linked with Fw gene which was further linked with RAPD marker OP-C04650 in repulsion phase and OPB-17800 and OPD-15500 in coupling phase. By converting them into SCAR markers, these RAPD markers can be made more useful to be used in marker-assisted breeding of lentil. Hamwieh et al. (2005) further studied about Fw gene and identified two linked markers, i.e., SSR59-2B (at 8.0 cM) and AFLP marker p17m30710 (3.5 cM). However, in India, mapping of wilt-resistant genes is yet to be done, and works are in progress by making populations crossing Precoz and Sehore 74-3 (susceptible) with PL 2 and IPL406 (resistant). If the genes will be mapped without any segregation distortion, it will be very useful in the Indian context (Solanki et al. 2010). According to Choudhary et al. (2013), work is going on in ICARDA for mapping the race-specific genes.
11.5 Ascochyta Blight
11.5.1 Introduction
Ascochyta blight, which is one of the most devastating biotic production constraints of lentil, is caused by Ascochyta lentis. It can attack the crop at any growth stage and to any plant part above the ground under advantageous conditions. The disease has been reported to cause loss in seed quality and yield up to 70% in Canada, 30–50% in the USA, and 50% in Australia (Gossen and Morrall 1983; Kaiser 1992; Brouwer et al. 1995). The pathogen has two stages in its life cycle, i.e., asexual stage represented by pycnidia found in lesions of infected plants which release cylindrical septate conidia and the sexual phage (Divdvmella lentis) which was found to be heterothallic in nature (Kaiser et al. 1997) and produce ascospores. Kaiser and Hellier (1993) in Idaho, USA, for the first time, reported the sexual form of the pathogen in the wintered lentil straw in 1992.
11.5.2 Disease Symptoms
The disease symptom starts with irregularly shaped lesions on pods, stem, leaves, and petioles. The color of the lesions is tan in leaves, stem, and petioles while dark brown on the seed and pods. On heavy infection, the lesions merge to girdle the stem, and the part above it break and die up by wilting. On older lesions, pycnidia can be found at the center, while seeds become wrinkled and bleached with whitish mycelium (Kaiser and Hannan 1986). Symptoms first appear on the leaves and spread up on the plant parts near the soil near the flowering stage. Later the leaves dry up and shed off.
11.5.3 Epidemiology
The disease is seed borne (Kaiser and Hannan 1986) and spread by wind (long distances) or rain splashes (15 cM) (Pedersen et al. 1994). Experiment by Kaiser et al. (1997) showed that the pathogen is able to survive on infected seed as long as the seed remain viable, while some scientists proposed that A. lentis loses its viability after 29 weeks on pods and 21 weeks on seed when buried in soil. The pathogen survives by its sexual/asexual form through the infected seeds, leaflets, and plant debris. Roundhill et al. (1995) studied the early infection process of pathogen by inoculating conidia suspension on the detached leaves. He observed conidia germination, appresoria within 6 and 10 h of inoculation, respectively. Then he found the penetration peg piercing the cuticle mostly near the link of two epidermal cells. A disrupted plasmalemma and broken nucleus and cytoplasm were observed after 40 and 52 h of infection. By day 9, the pathogen enters the mesophyll cells after covering the entire epidermal layer, and the macroscopic symptoms become evident.
11.5.4 Mitigation Strategies
Among the cultural practices, crop rotation, the use of disease-free seed, early sowing to avoid moist weather, and destroying the diseased debris are very useful to control the disease (Nene 1988). Dry heat treatment (70 °C for 24 h), hot water treatment (55 °C for 25 min), and sun drying of lentil seed have been found to be very effective in controlling the seed-borne infection, while hot water treatment drastically decreases the seed germination (Ahmed and Beniwal 1991; Beniwal 1989). Among the fungicides used for seed treatment, metalaxyl, thiram (Bretag 1989), benomyl, and thiobendazole (Kaiser and Hannan 1987) are found to be very effective to control the disease, while their foliar sprays were not found to be much effective. At 3 g or more AI/kg of seed thiobendazole, if applied, showed phytotoxic effects. At early bloom or pod setting stage, the foliar fungicides were found to be very effective even on a single application. Captafol, folpet, chlorothalonil, and metiram are some of the foliar fungicides recommended to control A. lentis (Beauchamp et al. 1986).
Study by Ahmed and Morrall (1996) reported that over the time, virulence of the pathogen increases possibly due to genetic recombination and/or natural selection for virulent pathotypes during host pathogen interaction. Vandenberg et al. (2006) found out natural diversity of aggressiveness in a pathogen population without any discrete pathotype and host specificity. Nasir and Bretag (1997) for the first time divided A. lentis isolates into six pathotypes. This helped in finding resistance sources in lentil germplasm for A. lentis where success has been reported in wild L. orientalis, L. nigricans, L. odemensis, and L. ervoides (Table 11.2) (Bayaa et al. 1994). Resistance sources such as Indianhead, ILL358, ILL857, ILL5562, ILL5588, ILL5684, ILL5883, and ILL6024 have been used as donors, and prominent varieties such as Pant L406 in India; Masoor 93 in Pakistan; Laird, CDC Redwing, CDC Milestone and CDC Matador in Canada; and Nugget, Nipper, and Cassab in Australia have been developed. Markers AbR1, SCAR W19, and RB18 developed by Ford et al. (1999) are one of the fore most attempts to start MAS in lentil for Ascochyta blight resistance. Similarly, UBC227 (ral2), OPD 10 (Chowdhury et al. 2001), and QTLs C-TT/M-AC (QTL1 and 2) and M20 (QTL 3) (Rubeena et al. 2003) were also found out for Ascochyta blight resistance. Tullu et al. 2006a) developed four markers for identifying QTL for seedling resistance to A. lentis (ITAP marker DK 225, SSR AC097a, ISSR UBC890a, and RAPD V20a) and four for resistance to pod blight (SSR ILMs 25, ISSRs UBC 855a, UBC 807a, and UBC 830b). Two more markers for seedling resistance (P06a and V14a) were also identified by Tullu et al. (2006a).
11.6 Anthracnose
11.6.1 Introduction
Colletotrichum truncatum f.sp. lentis is the causal organism of anthracnose in all legumes including lentil (Kaiser et al. 1998). It was isolated by Andrus and Moore from the infected lentil stem in 1992. During the maturing season, warm, humid, and wet climatic condition favors the disease development with an optimum temperature of 20–24 °C, and spread is mediated by wind and water splashes. Dense canopy, disease debris, and infested seed are the important means of recurrence of disease from one season to another. The pathogen produces microsclerotia which are the resting structure and able to survive up to 4 years in soil which germinate to infect the suitable host on onset of favorable conditions.
11.6.2 Disease Symptoms
As the disease starts, light brown to tan-colored lesions appear on the stem in the lower part. The lesions have black dots, and as the disease advances, it covers larger area and spread upward. On the leaves, symptoms become evident near to flowering on 8–12 node stage, and they fall off prematurely. On the pods, lesions of light to dark brown colored with dark margin are produced with discolored seeds within the pod. In stem, it shows girdling symptom with evident wilting and dying and dead plant blacken on severe infection conditions (Buchwaldt et al. 2018).
11.6.3 Epidemiology
The pathogen is polycyclic, and conidia are the repeating structures which are spread through the wind and rain splashes (Buchwaldt et al. 2018). By biphasic intracellular hemibiotrophic infection strategy, the pathogen colonizes the crop. The asexual spore, conidia under favorable condition, germinates on the host tissue to form a round melanized appressorium from which infection peg emerges to rupture the host tissue by forming an infection vesicle. Unlike other biotrophic and hemibiotrophic fungi, this pathogen has weak plant-pathogen interphase (Bhadauria et al. 2011). The extent of biotrophic phase depends on the temperature and humidity conditions and is asymptomatic. The necrotrophic phase is symptomatic and characterized by secondary hypha developed from primary hypha of biotrophic phase. The water-soaked lesions which had started with infection cycle turn into necrotic lesions (Bhadauria et al. 2015). The acervuli on the lesions produce orange to salmon colored, single-celled conidia, and the whole process takes a total of 7 days. The conidia serve as the secondary inoculum, and pathogen thus completes multiple life cycles in a single cropping season (Chongo et al. 2002).
11.6.4 Mitigation Strategies
Using disease-free seeds, removing diseased plants, avoiding the harvesting in wet conditions, and removing the slightly diseased pods help in controlling the disease effectively. 50% chlorothalonil at 0.8–1.6 L mixed with 90–640 L of water/acre is very useful to control the disease, and it is to be sprayed before the onset of disease. A second spray after a fortnight is recommended if the disease appears (https://cropgenebank.sgrp.cgiar.org/).
There are two races of Colletotrichum truncatum f.sp. lentis, i.e., Ct1 and Ct0, to which wild species L. nigricans, L. lamottei, L. odemensis, L. orientalis, and L. tomentosus are resistant to one or the other race, while L. ervoides is found to be resistant to both the races (Table 11.2) (Tullu et al. 2006b). Three dominant (CtR3, CtR4, and CtR5) and two recessive genes (ctr1 and ctr2) were found so far which control resistance to anthracnose in lentil (Buchwaldt et al. 2013). A Colletotrichum truncatum-resistant locus LCt-2 was also identified by Tullu et al. (2003) for which three AFLP markers (EMCTTACA350 and EMCTTAGG375 in coupling; EMCTAAAG175 in repulsion) and two RAPD markers (OPE061250 in repulsion and UBC-704700 in coupling) were also found out. Some resistant varieties such as Indianhead, PI320937, and PI345629 are released which are showing resistant to race Ct1.
11.7 Botrytis Gray Mold
11.7.1 Introduction
Botrytis cinerea Ex Fr. and Botrytis fabae Sard are reported to cause Botrytis gray mold disease (Erskine and Bayaa 1996; Davidson and Krysinska-Kaczmarek 2007). Botrytis cinerea is ubiquitous and nonspecific with a host range of over 200 plant species (Ellis and Waller 1974), while Botrytis fabae is restricted to Fabaceae family mostly on lentil, faba bean, and common vetch. The disease has been reported in many countries such as Australia, Canada, Nepal, India, Pakistan, New Zealand, and Colombia. 50% yield loss to complete crop failure has been reported in severe disease conditions (Erskine and Bayaa 1996; Elad et al. 2004).
11.7.2 Disease Symptoms
The disease starts with dark green discrete lesions on the lower plant parts which turn grayish brown to cream-colored large patches with age infecting the whole leaflet. On severe infection, leaflets are shed off, and a furry layer of conidiophores comes to the stem and girdle it infecting the whole plant. Before onset of flowering and pod initiation, the plants die, and it can be seen as patches in the field (Erskine and Bayaa 1996). In dry conditions, conidia are released, and secondary spread is caused which further infects the flowers causing the flower death by forming gray mold. Infected pods too show gray-colored moldy growth and rot. The seed filling is very poor or shriveled, and discolored seeds are formed (Elad et al. 2004; Erskine and Bayaa 1996). When sowing is done with the infected seeds, gray mycelial growth on the hypocotyl of the seedling becomes evident causing seedling blight (Morrall 1997).
11.7.3 Epidemiology
Both the pathogens have similar white, cottony growth pattern which turns gray with age. Hyaline, ovoid-spherical, single-celled, thin-walled conidia are formed in clusters in the conidiophores. The size of conidia of B. cinerea is smaller than that of B. fabae, while the size of sclerotia is exactly opposite (Ellis and Waller 1974). The size and shape vary according to the environmental conditions. The favorable conditions are dense canopy, humid with temperature of 15–25 °C in which the disease can be an epidemic in a short span of time with the help of wind-borne conidia (Elad et al. 2004; Davidson and Krysinska-Kaczmarek 2007). Lentil is susceptible to the pathogen at almost every growth stage, but flowering and pod setting stage are economically more important. Although the mycelium can survive saprophytically in the diseased plant debris, the main resting structure is sclerotia which can survive a long time if buried in soil (Erskine and Bayaa 1996).
11.7.4 Mitigation Strategies
Among the cultural measures, avoiding dense canopy, delayed sowing, reduced seed rate while sowing, increased row spacing, weed control, optimum nitrogen use, crop rotation (3 years), destroying the disease debris, and the use of disease-free seed are most important (Erskine and Bayaa 1996; Elad et al. 2004). Among the fungicides, carboxin, chlorothalonnil, thiram, benomyl, or thiabendazole can be used as seed treatments to minimize seedling blight and the seed-borne infection. Carbendazim, mancozeb, vinclozolin, tridemorph, etc. can be used as foliar fungicides. However, care must be taken to prevent fungicide resistance as the pathogen evolves rapidly to synthetic or systemic fungicide (Erskine and Bayaa 1996). Breeding program is going on to develop varieties with better resistance to Botrytis gray mold.
Although the resistance mechanism is poorly understood in case of Botrytis gray mold, some resistant germplasm has been identified. A variety “Nipper” released in Australia shows resistance to both gray mold and Ascochyta blight (Materne et al. 2002). According to Kuchuran et al. (2003), CDC Redcap, CDC Milestone, and CDC Robin have been reported to show consistently lower disease incidence in artificial epidemic conditions. In Pakistan, are accessions, ILL6024, ILL6004, and ILL6016 (Erskine et al. 1994) and in Nepal are LG 171, LG198, Aarial, LN0038, and Simrik (Karki 1993), whereas in Canada, variety Indianhead (ILL418) and Matador (Materne et al. 2002) were found to show resistance to Botrytis gray mold.
11.8 Powdery Mildew
11.8.1 Introduction
The disease powdery mildew has several causal organisms such as Erysiphe pisi DC and Erysiphe polygoni DC which are ectoparasites and Leveillula taurica (Lev.) Arnaud, an endoparasite. According to Attanayake et al. (2009), it is also caused by Erysiphe trifolii. The disease has been reported in India, Ethiopia, Tanzania, Russia, Cyprus, Sudan, Syria, etc. India and Sudan are the hotspots for this disease. Due to dry weather conditions, Rajasthan became the most affected state in India due to powdery mildew. Although in greenhouse the disease can come at any growth stage, in the field, the disease mostly comes at flowering. In Trans-Himalayan regions of India (Lahaul Spiti and Sangla) and in Syria, the disease also comes in off-season nurseries of lentil (Attanayake et al. 2009).
11.8.2 Disease Symptoms
Symptoms are evident in the older leaves on the upper surface, where affine powdery, white growth mycelium and conidia initiate as small spots. The disease spreads rapidly and covers the entire leaflets, stem, and pods. On severe infection, the leaves shed off becoming dry and curled. The infected pod bears small and shriveled seed causing reduction in seed quality and yield (Beniwal et al. 1993).
11.8.3 Epidemiology
The asexual (anamorph) stage is responsible for disease proliferation and spread. The conidia are formed in clusters, and infection is spread by the means of wing and water splashes. Moderately high temperature and RH favor the disease development. The teleomorph stage of the pathogen is found in India and Sudan (Chitale 1981).
11.8.4 Mitigation Strategies
Cultural methods should be followed as described earlier in other diseases. Some fungicides, benomyl, tridemorph, karathane, calixin, were found to be effective when sprayed at recommended dose. As foliar sprays, some insecticides such as phoxim, triazophos, and quinalphos were also found to be effective in controlling the disease (Beniwal et al. 1993). Many resistant lentil genotypes were also developed by Tikoo et al. (2005) against powdery mildew.
Some wild accessions tested at CSKHPKV, Palampur, were found to be effective against the disease. Those are L. orientalis (ILWL 230, ILWL 476), L. odemensis (ILWL 39, ILWL 203 and IG 136788), and L. tomentosus (ILWL 480, ILWL 198) (Singh et al. 2020). Mildew resistance locus O (MLO) family genes were analyzed and mined by
Polanco et al. (2018), and two genes, namely, LcMLO1 and LcMLO3, were characterized for possible powdery mildew resistance in lentil wild germplasm. Not much has been carried out in powdery mildew research in lentil, but many institutions in Australia, Canada, and India have ongoing research projects to find out the genetics of resistance to this disease.
11.9 Sclerotinia White Mold
11.9.1 Introduction
Sclerotinia sclerotiorum (Lib.) De bary is the causal organism of white mold disease also known as stems rot of lentil. The pathogen is ubiquitous and has more than 400 host species from 75 families (Boland and Hall 1994). The disease is favored by high plant density, excessive growth, and high precipitation especially during flowering and pod setting (Akem et al. 2006).
11.9.2 Disease Symptoms
Bleached lesions are formed in stem, leaves, pods, and pedicels in the beginning of disease. Sometimes, these are covered by cottony white mycelium with occasional dark spots which are the resting structure, the sclerotia. If ascospores are germinated, then senescent flower petals are perfect sites for invasion. Infection on stem can result in wilting of the plants (Bolton et al. 2006).
11.9.3 Epidemiology
Sclerotia are black and round to elongate with about 1cm in length. Sclerotia can germinate myceliogenically and can rapidly grow over the host tissue. No spores are formed on microconidiophores. Carpogenic germination of sclerotia for which specific soil temperature and moisture are required (Morrall 1997) forms light to dark brown apothecia. Asci can be found on the upper layer of apothecia with eight elliptical to ovoid, unicellular, and hyaline ascospores (Bolton et al. 2006; Clarkson et al. 2003). Both the ascospores and sclerotia are able to start the primary infection. At maturity, the plants become more susceptible to this disease. When infected plant touches the healthy plants, cell wall-degrading enzymes and oxalic acid formed by the pathogen help in invasion of pathogen to healthy tissue and develop yellowish and bleached lesions. Sclerotia formed return to soil during harvesting and threshing and provide the inoculum for next season (Bolton et al. 2006).
11.9.4 Mitigation Strategies
Cultural methods have limited efficacy due to wide host range of pathogen, and the sclerotia once formed has very long survival period. Early fungicide application has been found to be effective in controlling flower and petal infection where as it is not always economical. Delayed fungicide application is often not recommended as it cannot penetrate lower plant canopy due to the dense foliage (Bolton et al. 2006).
11.10 Next-Generation Strategies for Resistance Breeding in Lentil
Global food security is the primary goal of agriculture to ensure enough agricultural production for continuously growing population. However, yield of majority of crop plants is still limited due to various biotic stresses. In terms of productivity, lentil lags significantly behind other legumes (Tiwari et al. 2022). Conventional breeding strategies for disease resistance in plants have been thoroughly utilized, and hence there is a need to use next-generation breeding strategies to develop crop plants for better resistance and yield. Next-generation breeding techniques have been successfully employed in major crop plants; however, for less studies, crop plants, such as lentil, conventional breeding methods are still being used (Kole et al. 2015). Classical breeding strategy involves the process of hybridization and continuous screening to develop an elite variety (Kumar et al. 2021). However, this strategy is of limited use due to genetic drag, hybridization bottlenecks, and its laborious nature. To overcome the shortcomings of classical methods, integration of next-generation sequencing data, high-throughput phenomics, and the use of artificial intelligence are necessary to develop improved cultivars. Plant genomics is a crucial component of next-generation breeding techniques and helps in identification and selection of superior alleles for plant breeding through genetic engineering and marker-assisted selection (MAS). Several efforts have been made in the recent past to develop genomic resources in lentil including development of SNP and SSR markers, transcriptomes, QTL mapping, etc. (Kumar et al. 2018; Singh et al. 2019; Ma et al. 2020; Gela et al. 2021; Singh et al. 2021). Genotyping data generated through NGS platforms along with high-throughput phenotyping data could accelerate precise identification of genomic regions controlling agronomical traits (Tiwari et al. 2022). So far, classical phenotyping methods are being utilized for screening of agronomically important traits; these methods are labor-intensive, less precise, and time-consuming. Recent development of advanced imaging-based phenotyping methods has been instrumental in generating accurate phenotyping data of complex quantitative traits. A HTP method for screening salt toxicity was developed and applied for screening 276 lentil accessions which demonstrated improved accuracy of image-based phenotyping method (Dikshit et al. 2020). Similarly, another study utilized digital RGB, hyperspectral, and multispectral imaging for identification of Aphanomyces root rot-resistant genotypes in lentil (Marzougui et al. 2019). Although several high-throughput phenotyping techniques have been developed, their use for lentil phenotyping studies is still very limited. Therefore, there is a need to develop precise multisensor phenotyping platforms for lentil. Data generated through these platforms could be integrated with NGS-based genotyping data for identification of QTL regions and markers through QTL mapping and GWAS studies. Several QTLs and markers have been identified in lentil with the advent of NGS-based sequencing platforms. Next step should be the conversion of these markers into breeder friendly PCR based markers and their utilization for future lentil breeding programs through marker-assisted selection. Further, regulatory role and mechanism of action for genes identified in QTL mapping studies could be investigated through transcriptomic studies. Also, several other strategies such as CRISPR-Cas-based gene editing, transgenics, speed breeding, mutation breeding, etc. could also be implemented in lentil breeding programs for developing improved cultivars.
11.11 Conclusion and Future Perspective
Considering the severity and occurrence of various diseases, the fungal diseases account for major losses in lentil production. After analysis of the mitigation practices used to control fungal diseases, it can be concluded that several countries use fungicides to control the diseases. Most of the times, this becomes uneconomical for the producer, while on the other hand, it may bring about increased levels of resistance among the pathogens leading to more virulent and fungicide resistant strains. Phytotoxicity and environmental deterioration are also becoming major problems, although the crop requires minimal fungicide application as compared to other cultivated cereals and legumes.
In the Indian context, occurrence of rust, Fusarium wilt, Ascochyta blight, and powdery mildew is widespread, while in terms of disease severity and history of crop damage, lentil is most devastated due to Fusarium wilt, Stemphylium blight, rust, and Botrytis gray mold. In case of lentil rust, the robust and reproducible STS and SNP markers need to be developed, whereas artificial inoculation procedure in greenhouse and in the offseason needs to be standardized for the disease screening purpose. In case of Fusarium wilt, standard race identification procedures need to be developed. Identification and resistance genes, their genetics and mechanism of resistance, need to be studied thoroughly. As this disease has no effect of fungicide application, resistance breeding needs to be strengthened.
Ascochyta blight is the most researched disease, and advances have been made on both conventional and molecular aspects including gene, marker, and QTL identification for resistance breeding programs. More focus is required on diseases like Stemphylium blight, powdery mildew, anthracnose, Botrytis gray mold, and Sclerotinia white mold to identify the markers and map the QTL and genic regions responsible for disease resistance. Resistance breeding must be focused on development of area-specific multiple disease-resistant varieties. Large-scale screening of germplasm for possible resistance to most diseases has helped in identifying known sources of resistance, and there is a need to utilize these in lentil improvement programs. Moreover major efforts focusing on minor diseases like wet and dry root rot, black root rot, bacterial spots, and viral diseases are desirable in order to counter possible future outbreaks.
References
Abbas A (1995) Variation in some cultural and physiological characters and host/pathogen interaction of Fusarium oxysporum f. sp. lentis, and inheritance of resistance to lentil wilt in Syria. Faculty Agric. Univ, Aleppo
Agarwal SC, Singh K, Lal SS (1993) Plant protection of lentil in India. In: Lentil in South Asia. International Center for Agricultural Research in the Dry Area, Aleppo, pp 147–165
Agrawal SC, Khare MN, Agrawal PS (1977) Control of lentil rust by use of fungicides [India]. Indian Phytopathol (India) 29(1):90–91
Ahmed S, Beniwal SPS (1991) Ascochyta blight of lentil and its control in Ethiopia. Int J Pest Manag 37(4):368–373
Ahmed S, Morrall RA (1996) Field reactions of lentil lines and cultivars to isolates of Ascochyta fabae f. sp. lentis. Can J Plant Pathol 18(4):362–369
Ahmed D, Shahab S (2017) Effect of different inoculum levels of Fusarium solani (Mart.) Sacc on plant growth, biochemical and nutrient parameters of lentil (Lens culinaris Medik.). Int J Agric Environ Biotech 10(2):239–243
Akem C, Bellar M, Bayaa B (2006) Comparative growth and pathogenicity of geographical isolates of Sclerotinia sclerotiorum on lentil genotypes. Plant Pathol J 5(1):67–71
Ali M, Gupta S (2012) Carrying capacity of Indian agriculture: pulse crops. Curr Sci 102:874–881
Amarowicz R, Pegg RB (2008) Legumes as a source of natural antioxidants. Eur J Lipid Sci Technol 110(10):865–878
Asghar MJ, Akhtar KP, Abbas G, Rizwan M, Iqbal M, Idrees M, Ali S, Aslam M, Aziz-ur-Rehman MR, Saleem U, Khan ME (2018) Identification of multiple sources of resistance in lentil against some potential fungal diseases. Pakistan J Agric Sci 55(4)
Attanayake RN, Glawe DA, Dugan FM, Chen W (2009) Erysiphe trifolii causing powdery mildew of lentil (Lens culinaris). Plant disease 93(8):797–803
Bakr MA (1991) Plant protection of lentil in Bangladesh. In: Proceedings of the seminar on lentil in South Asia, pp 11–15
Bashi E, Rotem J (1975) Host and biotic factors affecting sporulation of Stemphylium botryosum f. sp. lycopersici on tomatoes and of alternaria porri f. sp. solani on potatoes. Phytoparasitica 3(1):27–38
Bayaa B, Erskine W, Khoury L (1986) Survey of wilt damage on lentils in northwest Syria. Arab J Plant Protect
Bayaa B, Erskine W, Hamdi A (1994) Response of wild lentil to Ascochyta fabae f. sp. lentis from Syria. Genetic Res Crop Evolution 41(2):61–65
Bayaa B, Erskine W, Hamdi A (1995) Evaluation of a wild lentil collection for resistance to vascular wilt. Genetic Resources and Crop Evolution 42(3):231–235
Bayaa B, Erskine W, Singh M (1997) Screening lentil for resistance to Fusarium wilt: methodology and sources of resistance. Euphytica 98(1-2):69–74
Beauchamp CJ, Morrall RA, Slinkard AE (1986) The potential for control of ascochyta blight of lentil with foliar-applied fungicides. Canadian journal of plant pathology 8(3):354–359
Bejiga G, Tullu A, Tsegaye S, Ahmed S, Anbessa Y (1995) Evaluation of lentil genotypes (Lens culinaris L.) for resistance to rust (Ethiopia), Petria (Italy)
Bellar M, Kebabeh S (1983) A list of diseases, injuries and parasitic weeds of lentils in Syria (survey 1979-1980). Lens 10(1):30–31
Beniwal SPS (1989) Effect of sun drying of lentil seeds on the control of seed-borne Ascochyta lentis (Lens culinaris). Lentil Experimental News Service.
Beniwal SPS, Bayaa B, Weigand S, Makkouk KH, Saxena MC (1993) Field guide to lentil diseases and insect pests. International Center for Agricultural Research in the Dry Areas (ICARDA)
Bhadauria V, Banniza S, Vandenberg A, Selvaraj G, Wei Y (2011) Cataloging proteins putatively secreted during the biotrophy-necrotrophy transition of the anthracnose pathogen Colletotrichum truncatum. Plant Signal Behav 6(10):327
Bhadauria V, MacLachlan R, Pozniak C, Banniza S (2015) Candidate effectors contribute to race differentiation and virulence of the lentil anthracnose pathogen Colletotrichum lentis. BMC genomics 16(1):628
Bhadauria V, Ramsay L, Bett KE, Banniza S (2017) QTL mapping reveals genetic determinants of fungal disease resistance in the wild lentil species Lens ervoides. Sci Rep 7(1):1–9
Boland GJ, Hall R (1994) Index of plant hosts of Sclerotinia sclerotiorum. Can J Plant Pathol 16(2):93–108
Bolton MD, Thomma BP, Nelson BD (2006) Sclerotinia sclerotiorum (Lib.) de Bary: biology and molecular traits of a cosmopolitan pathogen. Mol Plant Pathol 7(1):1–16
Booth C, Pirozynski KA (1967) Pleospora herharuni. C.M.I. Descriptions of Pathogenic Fungi and Bacteria, No. 150
Bowden RL, Wiese MV, Crock JE, Auld DL (1985) Root rot of chickpeas and lentils caused by Thielaviopsis basicola. Plant disease 69(12):1089–1091
Bretag TW (1989) Evaluation of fungicides for the control of ascochyta blight in lentils. Ann Appl Biol 114:44–45
Brouwer JB, Bretag TW, Materne MA (1995) Coordinated improvement program for Australian lentils. In: 2nd European conference on grain legumes, Copenhagen, Denmark, p 25
Buchwaldt L, Shaikh R, Adam J, Tullu A, Slinkard AE (2013) Recessive and dominant genes confer resistance to Colletotrichum truncatum in cultivated lentil. Can J Plant Pathol 35(2):222–231
Buchwaldt L, Dzananovic E, Durkin J (2018) Lentil anthracnose: epidemiology, fungicide decision support system, resistance and pathogen races. Can J Plant Pathol 40(2):189–198
Chahota RK, Gupta VP, Sharma SK (2002) Inheritance of rust resistance in lentil (Lens culinaris Medik.). Indian J Genet Plant Breed 62(3):226–227
Chaudhary RG (2008) Pathogenic variability in Fusarium oxysporum f. sp. lentis. Pulses Newsl 19(4):3
Chaudhary RG, Kaur A (2002) Wilt disease as a cause of shift from lentil cultivation in Sangod Tehsil of Kota (Rajasthan). Indian J Pulse Res 15(2):193–194
Chen W, Basandrai AK, Basandrai D, Banniza S, Bayaa B, Buchwaldt L, Davidson J, Larsen R, Rubiales D, Taylor PW (2009) 17 Diseases and their Management. In: The Lentil, p 262
Chitale K. (1981) Perfect stage of Erysiphe polygoni on lentil from India.
Chongo G, Gossen BD, Bernier CC (2002) Infection by Colletotrichum truncatum in resistant and susceptible lentil genotypes. Canadian Journal of Plant Pathology 24(1):81–85
Choudhary AK, Kumar S, Patil BS, Sharma M, Kemal S, Ontagodi TP, Datta S, Patil P, Chaturvedi SK, Sultana R, Hegde VS (2013) Narrowing yield gaps through genetic improvement for Fusarium wilt resistance in three pulse crops of the semi-arid tropics. SABRAO J Breed Genet 45(03):341–370
Chowdhury AM, Ahmed A, Zaman M (1997) Studies on the defence structural factors of some susceptible and resistant varieties of lentil plants. J Mycopathological Research 35:35–40
Chowdhury MA, Andrahennadi CP, Slinkard AE, Vandenberg A (2001) RAPD and SCAR markers for resistance to ascochyta blight in lentil. Euphytica 118(3):331–337
Clarkson JP, Staveley J, Phelps K, Young CS, Whipps JM (2003) Ascospore release and survival in Sclerotinia sclerotiorum. Mycological Res 107(2):213–222
Coyne C, McGee R (2013) Lentil. In: Genetic and genomic resources of grain legume improvement, pp 157–180
Datta S, Rai R, Dhar V, Chaudhary RG, Gurha SN (2009) RAPD based diagnosis and diversity analysis of Fusarium wilt pathogen of pulse crops. J Food Legum 22(2):77–81
Davidson JA, Krysinska-Kaczmarek M (2007) Effects of inoculum concentration, temperature, plant age and interrupted wetness on infection of lentil (Lens culinaris) by Botrytis spp. conidia. Australas Plant Pathol 36(4):389–396
De RK, Ali SS, Dwivedi RP (2001) Effect of interaction between Fusarium oxysporum f. sp. lentis and Meloidogyne javanica on lentil. Indian J Pulse Res 14(1):71–73
Dikshit HK, Sharma TR et al (2016) Tagging and mapping of SSR marker for rust resistance gene in lentil (Lens culinaris Medikus subsp. culinaris). Indian J Exp Biol 54(6):394–399
Dikshit HK, Singh A, Singh D, Aski M, Jain N, Hegde VS, Basandrai AK, Dissanayake R, Kahrood HV, Dimech AM, Noy DM, Rosewarne GM, Smith KF, Cogan NO, Kaur S (2020) Development and application of image-based high-throughput phenotyping methodology for salt tolerance in lentils. Agronomy 10(12):1992
Duenas M, Hernandez T, Estrella I (2006) Assessment of in vitro antioxidant capacity of the seed coat and the cotyledon of legumes in relation to their phenolic contents. Food Chemistry 98(1):95–103
Elad Y, Williamson B, Tudzynski P, Delen N (eds) (2004) Botrytis: biology, pathology and control. Springer Science & Business Media
El-Hassan SA, Gowen SR (2006) Formulation and delivery of the bacterial antagonist Bacillus subtilis for management of lentil vascular wilt caused by Fusarium oxysporum f. sp. lentis. J Phytopathol 154(3):148–155
Ellis MB, Waller JM (1974) Sclerotinia fuckeliana (conidial state: Botrytis cinerea). In: CMI descriptions of pathogenic fungi and bacteria
Erskine W (2009) The lentil: botany, production and uses. CABI
Erskine W, Bayaa B (1996) Yield loss, incidence and inoculum density associated with vascular wilt of lentil. Phytopathologia Mediterranea 35:24–32
Erskine W, Tufail M, Russell A, Tyagi MC, Rahman MM, Saxena MC (1994) Current status and future strategy in breeding lentil for resistance to biotic and abiotic stresses. In: Muehlbauer FJ, Kaiser WJ (eds) Expanding the Production and Use of Cool Season Food Legumes
Eujayl I, Erskine W, Bayaa B, Baum M, Pehu E (1998) Fusarium vascular wilt in lentil: inheritance and identification of DNA markers for resistance. Plant breeding 117(5):497–499
Fiala JV, Tullu A, Banniza S, Séguin-Swartz G, Vandenberg A (2009) Interspecies transfer of resistance to anthracnose in lentil (Lens culinaris Medic.). Crop Science 49(3):825–830
Fikre A, Sarker A, Ahmed S, Ali K, Erskine W (2007) Registration of ‘Teshale’ Lentil. J Plant Reg 1(1):45
Ford R, Pang ECK, Taylor PWJ (1999) Genetics of resistance to ascochyta blight (Ascochyta lentis) of lentil and the identification of closely linked RAPD markers. Theoretical and Applied Genetics 98(1):93–98
Gela TS, Koh CS, Caron CT, Chen LA, Vandenberg A, Bett KE (2021) QTL mapping of lentil anthracnose (Colletotrichum lentis) resistance from Lens ervoides accession IG 72815 in an interspecific RIL population. Euphytica 217(4):1–11
Gilchrist DG (1990) Stemphylium leaf spot. In: Compendium of Alfalfa diseases, 2nd edn, pp 17–20
Gossen BD, Morrall RAA (1983) Effect of ascochyta blight on seed yield and quality of lentils. Can J Plant Pathol 5(3):168–173
Gupta D, Sharma SK (2006) Evaluation of wild Lens taxa for agro-morphological traits, fungal diseases and moisture stress in North Western Indian Hills. Genet Resour Crop Evol 53(6):1233–1241
Gupta M, Verma B, Kumar N, Chahota RK, Rathour R, Sharma SK, Bhatia S, Sharma TR (2012) Construction of intersubspecific molecular genetic map of lentil based on ISSR, RAPD and SSR markers. J Genet 91(3):279–287
Hamwieh A, Udupa SM, Choumane W, Sarker A, Dreyer F, Jung C, Baum M (2005) A genetic linkage map of Lens sp. based on microsatellite and AFLP markers and the localization of fusarium vascular wilt resistance. Theor Appl Genet 110(4):669–677
Kaiser WJ (1992) Fungi associated with the seeds of commercial lentils from the US Pacific Northwest. Plant Dis 76(6):605–610
Kaiser WJ, Hannan RM (1986) Incidence of seed borne Ascochyta lentis in lentil germ plasm. Phytopathol 76(3):355–360
Kaiser WJ, Hannan RM (1987) Seed-treatment fungicides for control of seedborne Ascochyta lentis on lentil. Plant Dis 71(1):58–62
Kaiser WJ, Hellier BC (1993) Didymella sp., the teleomorph of Ascochyta lentis on lentil straw. Phytopathol 83:692
Kaiser WJ, Wang BC, Rogers JD (1997) Ascochyta fabae and A. lentis: host specificity, teleomorphs (Didymella), hybrid analysis, and taxonomic status. Plant Dis 81(7):809–816
Kaiser WJ, Mihov M, Muehlbauer FJ, Hannan RM (1998) First report of anthracnose of lentil incited by Colletotrichum truncatum in Bulgaria. Plant Dis 82(1):128–128
Kamboj RK, Pandey MP, Chaube HS (1990) Inheritance of resistance to Fusarium wilt in Indian lentil germplasm (Lens culinaris Medik.). Euphytica 50(2):113–117
Karahan A, Katırcıoğlu YZ (1993) Occurrence and distribution of fungal diseases on lentil in Ankara Province. J Turk Phytopathol 22(1):27–33
Karki PB (1993) In: Erskine W, Saxena MC (eds) Plant protection of lentil in Nepal. Lentil in South Asia, pp 187–193
Khare MN (1980) Wilt of lentil. Jawaharlal Nehru Krishi Vishwa Vidyalaya, Jabalpur, Madhya Pradesh
Khare MN (1981) Diseases of lentils
Koike ST, Henderson DM, Butler EE (2001) Leaf spot disease of spinach in California caused by Stemphylium botryosum. Plant Dis 85(2):126–130
Kole C, Muthamilarasan M, Henry R, Edwards D, Sharma R, Abberton M, Batley J, Bentley A, Blakeney M, Bryant J, Cai H (2015) Application of genomics-assisted breeding for generation of climate resilient crops: progress and prospects. Front Plant Sci 6:563
Kuchuran M, Banniza S, Vandenberg B (2003) Evaluation of lentil varieties for resistance to botrytis grey mould. In: ‘Meeting the challenge: opportunities and pressures within the pulse industry. Proceedings of Pulse Field Days, Saskatoon, pp 6–7
Kumar P (2007) Genetics of resistance to Stemphylium leaf blight of lentil (Lens culinaris) in the Barimasur-4× CDC Milestone. (Doctoral dissertation, Thesis of Masters of Science, Department of Plant Sciences, University of Saskatchewan, Saskatoon).
Kumar R, Mishra SK, Sharma B (2001) Genetics of rust resistance in lentil (Lens culinaris Medik.). Ratio 151(122):29
Kumar S, Kumar J, Singh S, Ahmed S, Chaudhary RG, Sarker A (2010) Vascular wilt disease of lentil: a review. J Lentil Res 4:1–14
Kumar A, Bal RS, Gill RK, Singh S (2015) Incorporation of resistance against rust (Uromyces viciae-fabae) in lentil. J Food Legum 28(2):13–14
Kumar J, Gupta S, Gupta DS, Singh NP (2018) Identification of QTLs for agronomic traits using association mapping in lentil. Euphytica 214(4):1–15
Kumar J, Sen Gupta D, Baum M, Varshney RK, Kumar S (2021) Genomics-assisted lentil breeding: Current status and future strategies. Legum Sci 3(3):e71
Ladizinsky G (1979) The origin of lentil and its wild gene pool. Euphytica 28(1):179–187
Lamari L, Bernier CC (1985) Etiology of seedling blight and root rot of faba bean (Vicia faba) in Manitoba. Can J Plant Pathol 7(2):139–145
Ma Y, Marzougui A, Coyne CJ, Sankaran S, Main D, Porter LD, Mugabe D, Smitchger JA, Zhang C, Amin MN, Rasheed N (2020) Dissecting the genetic architecture of Aphanomyces root rot resistance in lentil by QTL mapping and genome-wide association study. Int J Mol Sci 21(6):2129
Marzougui A, Ma Y, Zhang C, McGee RJ, Coyne CJ, Main D, Sankaran S (2019) Advanced imaging for quantitative evaluation of Aphanomyces root rot resistance in lentil. Front Plant Sci 10:383
Materne MA , McMurray L , Nitschke S , Regan K , Heuke L , Dean G , Carpenter D (2002) The future of Australian lentil production. In: ‘Proceedings of Lentil Focus 2002’. Horsham, Vic. (Ed. JB Brouwer) pp. 14–18
Mihov M, Stoyanova M (1998) Results from improving investigation in lentil breeding in Bulgaria. “Rasteniev” dni Nauki 35(1):18–21
Mittal RK (1997) Effect of sowing dates and disease development in lentil as sole and mixed crop with wheat. J Mycol Plant Pathol 27(2):203–209
Mohammadi N, Puralibaba H, Goltapeh EM, Ahari AB, Sardrood BP (2012) Advanced lentil lines screened for resistance to Fusarium oxysporum f. sp. lentis under greenhouse and field conditions. Phytoparasitica 40(1):69–76
Morrall RAA (1997) Evolution of lentil diseases over 25 years in western Canada. Can J Plant Pathol 19(2):197–207
Morrall RAA (2003) Diseases of Lentil. In: Bailey KL, Gossen BD, Gugel RK, Morrall RAA (eds) Diseases of Field Crops in Canada, 3rd edn. The Canadian Phytopathological Society, pp 191–200
Mwakutuya E (2006) Epidemiology of Stemphylium Blight on Lentil ('Lens Culinaris') in Saskatchewan. (Doctoral dissertation. University of Saskatchewan)
Nasir M, Bretag TW (1997) Pathogenic variability in Australian isolates of Ascochyta lentis. Australas. Plant Pathol. 26:217–220
Negussie T, Pretorius ZA (2012) Lentil rust: present status and future prospects. Crop Prot 32:119–128
Negussie T, Pretorius ZA, Bender CM (2005) Components of rust resistance in lentil. Euphytica 142(1-2):55–64
Nene YL (1988) Multiple-disease resistance in grain legumes. Ann Rev Phytopathol 26(1):203–217
Nguyen TT, Taylor PWJ, Brouwer JB, Pang ECK, Ford R (2001) A novel source of resistance in lentil (Lens culinaris ssp. culinaris) to ascochyta blight caused by Ascochyta lentis. Aus Plant Pathol 30(3):211–215
Paulitz TC, Huang HC, Gracia-Garza JA (2002) Pythium spp., damping-off, root and crown rot (Pythiaceae). In: Mason PG, Huber JT (eds) Biological Control Programmes in Canada 1981– 2000. CABI Publishers, Wallingford, UK, pp 478–483
Pedersen EA, Morrall RAA, McCartney HA, Fitt BD (1994) Dispersal of conidia of Ascochyta fabae f. sp. lentis from infected lentil plants by simulated wind and rain. Plant Pathol 43(1):50–55
Peñaloza E, Tay JU, France AI (2007) Calpun-INIA, a large seed size and rust-resistant lentil (Lens culinaris Medik.) cultivar. Agricultura Técnica 67(1):68–71
Podder R, Banniza S, Vandenberg A (2013) Screening of wild and cultivated lentil germplasm for resistance to Stemphylium blight. Plant Genetic Resour 11(1):26–35
Polanco C, de Miera LES, Bett K, de la Vega MP (2018) A genome-wide identification and comparative analysis of the lentil MLO genes. PloS One 13(3):e0194945
Prasada R, Verma UN (1948) Studies on Lentil rust, Uromyces fabae (Pers.) de Bary, in India. Indian Phytopathol 1(2):142–146
Reddy RR, Khare MN (1984) Further studies on factors influencing the mechanism of resistance in lentil (Lens culinaris M.) to rust (Uromyces fabae (Pers.) De Bary). Lentil Experimental News Service
Roundhill SJ, Fineran BA, Cole ALJ, Ingerfeld M (1995) Structural aspects of ascochyta blight of lentil. Can J Bot 73(3):485–497
Roy S, Ullah MA, Ghosh SR, Sarker PC, Islam R (2018) Binamasur-7: a released high yielding lentil variety in Bangladesh. Bangladesh J 34:45–50
Rubeena TP, Ford R, Taylor PWJ (2003) Molecular mapping the lentil (Lens culinaris) genome. Theor Appl Genet 107:910–916
Sadiq MS, Haidar S, Haq MA, Abbas G (2008) A high yielding and disease resistant mutant of lentil developed through seed irradiation of an exotic germplasm. Can J Pure Appl Sci 2(2):411
Saha GC, Sarker A, Chen W, Vandemark GJ, Muehlbauer FJ (2010a) Identification of markers associated with genes for rust resistance in Lens culinaris Medik. Euphytica 175(2):261–265
Saha GC, Sarker A, Chen W, Vandemark GJ, Muehlbauer FJ (2010b) Inheritance and linkage map positions of genes conferring resistance to stemphylium blight in lentil. Crop Sci 50(5):1831–1839
Sarker A, Erskine W, Hassan MS, Afzal MA, Murshed ANMM (1999a) Registration of Barimasur-4' Lentil. Crop Sci 39(3):876–876
Sarker A, Kumar J, Rahman MM, Hassan MS, Zaman W, Afzal MA, Murshed ANMM (1999b) Registration of Barimasur-3' Lentil. Crop Sci 39(5):1536–1536
Sharma MD, Mishra RP, Jain AC (1978) Cercospora lensii sp. Nov. A new species of Cercospora on lentil. Curr Sci 47:774–775
Singh K (1985) Effects of seed treatment on lentil rust (Uromyces fabae) development. Lens Newsl
Singh K, Sandhu TS (1988) Screening of cultivars of lentil for resistance to rust (Lens culinaris). Lentil Experimental News Service
Singh IS, Singh JP, Singh AK, Chauhan MP (1994) Pant Lentil 4: a high yielding, rust, wilt-and blight-resistant variety for the North-Western Plains of India. Lens Newsl 21(1):8–9
Singh K, Rawal HS, Singh S, Gumber RK (1995) Physiological specialization in Uromyces fabae causing rust of lentil. Lens Newsl 22:46–47
Singh A, Dikshit HK, Mishra GP, Aski M, Kumar S (2019) Association mapping for grain diameter and weight in lentil using SSR markers. Plant Gene 20:100204
Singh M, Kumar S, Basandrai AK, Basandrai D, Malhotra N, Saxena DR, Gupta D, Sarker A, Singh K (2020) Evaluation and identification of wild lentil accessions for enhancing genetic gains of cultivated varieties. PloS One 15(3):e0229554
Singh D, Singh CK, Taunk J, Sharma S, Gaikwad K, Singh V, Sanwal SK, Singh D, Sharma PC, Pal M (2021) Transcriptome skimming of lentil (Lens culinaris Medikus) cultivars with contrast reaction to salt stress. Funct Integr Genomics 21(1):139–156
Sinha JN, Singh AP (1991) Two new records. Indian Phytopathol 44(3):421
Sinha JN, Singh AP (1993) Effect of environment on the development and spread of Stemphylium blight of lentil. Indian Phytopathol 46(3):252–253
Sinha RP, Yadav BP (1988) Inheritance of resistance to rust in lentil. Lens Newsl 16(1):41
Smith OF (1940) Stemphylium leaf spot of Red Clover and Alfalfa. J Agric Res 12:831–846
Solanki RK, Singh S, Kumar J (2010) Molecular marker assisted testing of hybridity of F1 plants in lentil. J Food Legum 23(1):21–24
Tate KG (1970) A foliage disease of blue lupin caused by Stemphylium botryosum Wallr. New Zealand J Agric Res 13(3):710–716
Tikoo JL, Sharma B, Mishra SK, Dikshit HK (2005) Lentil (Lens culinaris L.) in India: present status and future perspectives. Indian J Agric Sci 75:539–562
Tiwari M, Singh B, Min D, Jagadish SK (2022) Omics path to increasing productivity in less-studied crops under changing climate—lentil a case study. Front Plant Sci 13:1239
Tullu A, Buchwaldt L, Warkentin T, Taran B, Vandenberg A (2003) Genetics of resistance to anthracnose and identification of AFLP and RAPD markers linked to the resistance gene in PI 320937 germplasm of lentil (Lens culinaris Medikus). Theor Appl Genet 106(3):428–434
Tullu A, Buchwaldt L, Lulsdorf M, Banniza S, Barlow B, Slinkard AE, Sarker A, Tar’an B, Warkentin T, Vandenberg A (2006a) Sources of resistance to anthracnose (Colletotrichum truncatum) in wild Lens species. Genet Resour Crop Evol 53(1):111–119
Tullu A, Tar'an B, Breitkreutz C, Banniza S, Warkentin TD, Vandenberg A, Buchwaldt L (2006b) A quantitative-trait locus for resistance to ascochyta blight (Ascochyta lentis) maps close to a gene for resistance to anthracnose (Colletotrichum truncatum) in lentil. Can J Plant Pathol 28(4):588–595
Tullu A, Diederichsen A, Suvorova G, Vandenberg A (2011) Genetic and genomic resources of lentil: status, use and prospects. Plant Genet Res 9(1):19–29
Vail S, Vandenberg A (2011) Genetic control of interspecific-derived and juvenile resistance in lentil to Colletotrichum truncatum. Crop Sci 51(4):1481–1490
Vail S, Strelioff JV, Tullu A, Vandenberg A (2012) Field evaluation of resistance to Colletotrichum truncatum in Lens culinaris, Lens ervoides, and Lens ervoides x Lens culinaris derivatives. Field Crop Res 126:145–151
Vandenberg A, Banniza S, Warkentin TD, Ife S, Barlow B, McHale S, Brolley B, Gan Y, McDonald C, Bandara M, Dueck S (2006) CDC Redberry lentil. Can J Plant Sci 86(2):497–498
Vishunavat K, Shukla P (1979) Fungi associated with lentil seed. Ind. Phytopath 32(2):279–280
Zou Y, Chang SK, Gu Y, Qian SY (2011) Antioxidant activity and phenolic compositions of lentil (Lens culinaris var. Morton) extract and its fractions. J Agric Food Chem 59(6):2268–2276
Author information
Authors and Affiliations
Corresponding author
Editor information
Editors and Affiliations
Rights and permissions
Copyright information
© 2023 The Author(s), under exclusive license to Springer Nature Singapore Pte Ltd.
About this chapter
Cite this chapter
Padhy, A.K., Singh, B., Bhatia, S. (2023). Understanding Fungal Diseases and Their Mitigation in Lentils. In: Jha, U.C., Nayyar, H., Sharma, K.D., von Wettberg, E.J.B., Singh, P., Siddique, K.H. (eds) Diseases in Legume Crops. Springer, Singapore. https://doi.org/10.1007/978-981-99-3358-7_11
Download citation
DOI: https://doi.org/10.1007/978-981-99-3358-7_11
Published:
Publisher Name: Springer, Singapore
Print ISBN: 978-981-99-3357-0
Online ISBN: 978-981-99-3358-7
eBook Packages: Biomedical and Life SciencesBiomedical and Life Sciences (R0)